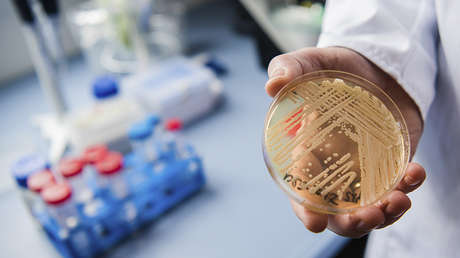
Hongos peligrosos: La resistencia a los medicamentos antimicóticos pone en peligro la salud humana

La aparición de hongos patógenos resistentes a medicamentos suponen una seria amenaza para el control de las enfermedades. Es decir, la salud humana y de los animales están en un verdadero riesgo, como así también los cultivos, entre otros. Se trata de hongos naturales que han logrado resistencia a una amplia clase de productos químicos.
En la actualidad, los fungicidas y antifúngicos se utilizan como tratamientos de primera línea para las enfermedades fúngicas en humanos y plantas. Pero ahora, científicos de la Escuela Imperial de Londres y de la Universidad de Exeter advierten que el control de los hongos patógenos podría convertirse en algo efímero, debido a su creciente capacidad de resistencia al empleo excesivo de los productos químicos.
Este descubrimiento prueba que los tratamientos son cada vez menos eficaces, hecho que a su vez podría conducir a un aumento mundial de enfermedades humanas producidas por hongos, así como a una mayor pérdida de cultivos alimentarios y de ganado.
Los hongos son igual de peligrosos que la tuberculosis o el VIH
En la actualidad, los efectos de los hongos en la salud humana son cada vez más significativos, y la tasa de mortalidad mundial por enfermedades causadas por hongos supera a la de la malaria o el cáncer de mama, e incluso es comparable a la tasa de muertes por tuberculosis y VIH.
Según la investigación, a pesar de su omnipresencia, las infecciones fúngicas han sido descuidadas en gran medida en comparación con otras clases de enfermedades infecciosas.
Los especialistas subrayan que para evitar un "colapso global" se necesita un mayor enfoque en el descubrimiento de nuevos tratamientos. No obstante, "el número muy limitado de medicamentos antimicóticos demuestra que el surgimiento de la resistencia a los hongos está llevando a que muchas infecciones fúngicas comunes se conviertan en incurables", afirmó Matthew Fisher, autor del estudio.